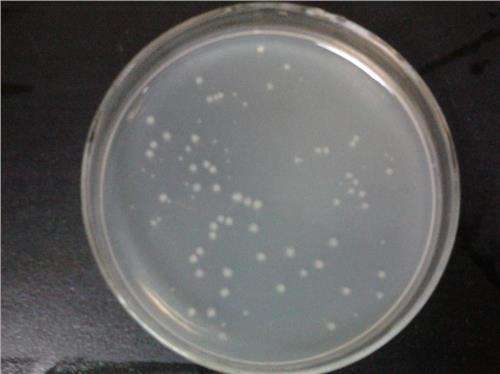
脑心浸出液肉汤

1688工业品为您提供在线免费查询更多履带挖掘机详细参数、实时报价、规格一览表。更多关于履带挖掘机多少钱一台/履带挖掘机报价明细/履带挖掘机规格型号表/履带挖掘机价格一览表/履带挖掘机官方报价等咨询,尽在1688工业品。询底价>
为你找到生物化工相关产品

批发彩色硬珍珠 洗手液磨砂膏可溶彩色颗粒 霍霍巴粒子
¥266
售10+千克
广东广州
在线询价
脑心浸出液肉汤
¥120
售10+
上海
在线询价

中石油油田入网石油钻井级黄原胶差厂家直销
¥16
河北沧州
在线询价

厂家直供 优质甘肃甘草酸二钾化妆品级含量98%品质保证国产精品
¥740
售10+千克
广东广州
在线询价

供应化妆品 悬浮稳定剂 SF-1 液体卡波 悬浮稳定增稠剂
¥26
售10+千克
广东广州
在线询价

鸡血藤肽 水溶 鸡血藤提取物 酶解蛋白 小分子肽 食品级 厂家现货
¥165
售10+袋
陕西西安
在线询价

依克多因98%【100g】四氢嘧啶 四氢甲基嘧啶羧酸CAS:96702-03-3
¥750
售10+袋
陕西西安
在线询价

供应 有机冷压 琼崖海棠油 Tamanu 马达加斯加 海棠油 1KG起订
¥550
售10+千克
广东广州
在线询价

浙江环烷酸镍生产厂家61788-71-4 环烷酸镍1kg起订包邮 环烷酸镍
¥140
售10+千克
浙江温州
在线询价

法国 燕麦葡聚糖 保湿护肤 化妆品原料 100ML
¥60

广东广州
在线询价

Liponic EG-1 PEG-26甘油醚 美国莱宝康 化妆品DIY保湿润肤剂
¥50
售10+千克
广东广州
在线询价

现货供应 磷脂食品级含量20kg起订
¥23
售10+千克
河南郑州
在线询价
相关商品推荐
PCA铜 吡咯烷酮羧酸铜 保湿 护肤 化妆品原料 100g蔓越莓果汁粉 蔓越橘粉100目 水果汁粉 蔓越莓提取物花青素1kg韩国 蜗牛提取液 萃取液 蜗牛分泌物滤液 100g美国杜邦 甘醇酸 科慕乙醇酸(AHA)护肤果酸 分装500g/袋原料
北京 蘑菇葡聚糖 保湿护肤 化妆品原料 1Kg包邮 冻干粉菌种 里拉微球菌 编号SHBCC D10390厂家直销沐浴露用双色花瓣营养花瓣可溶解多肽一公斤起订红抗氧化五味子提取物10%规格 五味子总素 南五味子素 唐门生物 现货供应
拓丰供应叶黄素油10%万寿菊油 油状叶黄素万寿菊提取物1kg/瓶包邮蔬菜甘油植物甘油天然甘油丙三醇护肤用保湿滋润1kg保湿神器胡萝卜粉 水溶胡萝卜粉 红萝卜粉 蔬菜粉 夏州生物 kg装月见草油 晚樱草油 按摩油 护肤 化妆品原料 1Kg





